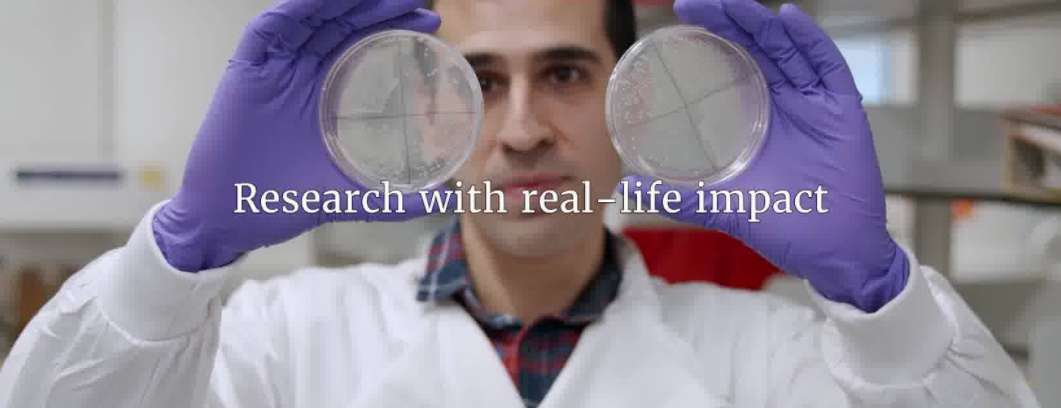
Nonprofit 2

Hospice Angelus Moldova Foundation




Health & Help




Aravind Eye Foundation





Community Coalition for Haiti (CCH)




Flame




Sight.org




Canwinn Foundation




Haiti Eye Mission

Partners for Visual Health




Sheptytsky Hospital Charitable Fund



Project Pacer International




Bangladesh Health Development Initiative (BHDI)




Funmi Adewole Foundation, The (FAF)


Hands Across Oceans




Australian Doctors International (ADI)




Friends of Mandritsara Trust




Lily Project, The




Trinh Foundation Australia





Hamlin Fistula Ethiopia





Partners in Compassionate Care